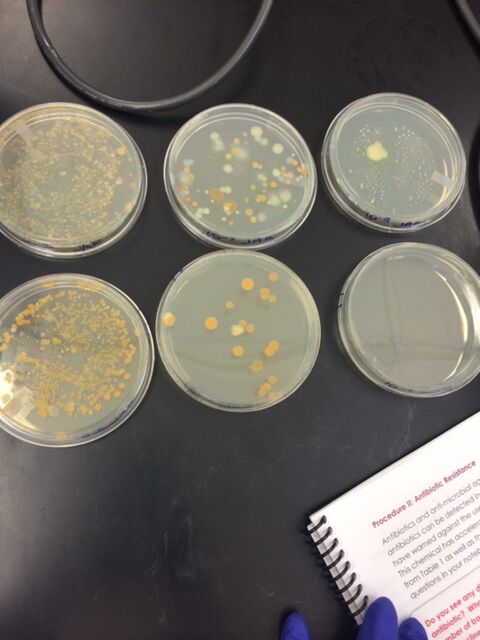

User:Roshni Jain/Notebook/Biology 210 at AU
Embryology and Zebrafish UPDATE 3/12/15
On day 11, the lab was closed so we did not get to observe our zebrafish.
On day 14, we observed the zebrafish that were fixed using the microscope at 10x.
The control fish grew normally, it was lighter colored than the tested and was spotted. It was about 4 mm long, with the eye being about .14 mm big and the swim bladder being .45 mm big. It had a normal shape to it and was not distorted like the tested fish was. Here is a picture of the control fish : 
On the other hand, the tested fish had a distorted shape. It's body was ruptured and shriveled and was a darker colored than the control zebrafish. It's left eye was ruptured as well. It's average size was about .56 mm big. There was no identification of it's organs, however, it's eyes grew a lot more than than control group had. The eyes were bigger and were more ruptured than the control group zebrafish. Here is a picture of the tested zebrafish: 
The zebrafish were harshly affected when tested with ethisterone. Their organs were not visible, however, the eyes were ruptured and grew at a faster pace than the control. Overall, it's body was shriveled up and distorted unlike the control group. The observations made throughout this experiment from the past 2 weeks supports the hypothesis that the zebrafish affected by ethisterone mature behaviorally faster than the zebrafish not impacted by this progestin. The response and reaction rate is a lot quicker of the test zebrafish than the control fish. The ethisterone made the zebrafish a lot more sensitive to its surroundings, including the petri dish as well as light hitting the fish. It's organs also grew to a size bigger than those of the control fish. However, if we had more time, many more observations could have been made to further support our hypothesis. This experiment is also very prone to human error. Mainly because we may have not added the exact correct amount of ethisterone each day. We also did not get to observe the fish on day 11-- a day where we could have made more observations before they all died on day 14. We may also have identified the organs wrong and we could not measure the heart beat of the fish which could have been a huge observation made because the fish were swimming way too fast. These observations made will definitely be beneficial to humans because we now know how ethisterone negatively impacts embryos and the hatchlings. Humans can lean the limitations and negative impacts of this progestin so pregnant women can be lot more careful when ingesting these hormones.
RJ
4.7.15 Good entry. A data table may have helped. SK
PCR for 16S Sequence 3/4/15
Purpose: This procedure was part of lab 3. PCR was set up in order to amplify and identify our bacteria from our agar plates and ultimately our Hay Infusion Culture and transect. We were able to identify our species after this PCR reaction was completed-- which were completely different than what we had identified our bacteria to be.
Materials and Methods: We chose one bacteria from a tetracycline plate and one without tetracycline. We then isolated them and transferred the bacteria into a sterile tube with with 100 microliters of water in it. The tube was incubated for 10 minutes in a heat block and then centrifuged for 5 minutes. While centrifugation, primer/water mixture was added to a PCR tube and mixed. We then transferred 5 microliters of the supernatant to the 16S PCR reaction and placed the tube into the PCR machine. We then ran the products on an agarose gel. Since we had a match (we could see a band), our DNA was sent out for sequencing.
Data and Observations: Here is a picture of the agarose gel on which we had ran the product from the PCR. As you can see (although very lightly) , there was a band which means our DNA was ready to be sequenced. We chose a bacteria from our white plate with tetracycline and one white plate without tetracycline.

When we had done this lab, we found different bacteria which looked nothing like what they actually are (which we found out from the PCR reaction).
Our white plate with tetracycline (MB 31) matched with Ralstonia Pickettii Strain KTO-35. Here is a picture of the DNA sequence of MB 31.

Our white plate without tetracycline (MB 38) matched with Pseudomonas Flourescens Strain S2. Here is a picture of the DNA sequence of MB 38.

Conclusion: For both of our agar plates, we had identified the the species as paramecium. However, we were completely wrong. Our white agar plate without tetracycline, which was identified as Pseudomonas Flourescens, was white, smooth/glistening, punctifom, undulated, cocci and rod shaped, small and swimming. It was also gram positive. Our white tetracycline plate, was identified as Ralstonia Pickettii. It was white, flat, smooth/glistening, punctiform, rod shaped, swimming/floating slowly, and brownian. This was gram negative. We may have confused them as paramecium because of the shape and other characteristics-- and due to human error, identified them wrong. Pseudomonas Flourescens "colonize soil, water, and plant surface environments" which is exactly what our transect consisted of (Palleroni). It is also stated that they are very well adapted to soil. Our transect was moist (because of the weather) and had a patch of soil and plants/bushes. They are also rod-shaped and have flagella to help them move, which is another characteristic we mistook for as a paramecium. Fortunately, they are also helpful to the environment by providing and preserving nutrients to the ecosystem. Ralstonia Pickettii are also gram negative, rod shaped, and found in moist and soil environments-- which makes sense as to why the are in our transect. They also form white colonies when experimented on and are found in several household chemical products (Palleroni). They are used for bioremediation and can survive in environments that consist of very low amounts of nutrients (Palleroni). The major reason why we confused and misidentified our species is because of the way they look-- their shape, size, way of motility. Their characteristics are very similar to those of paramecium. We may have not observed these species at the right magnification or not clear enough-- it is all due to human error. Our eyes may have seen something other than there was since the PCR product was completely different than what we had observed.
Citations: Adley C, Pembroke J, Ryan M. (Feb 2007) Ralstonia pickettii in environmental biotechnology potential and applications. Journal of Applied Microbiolgy. Vol 103. pp 754-764. Bentley, M., Walters-Conte, K., & Zeller, N. 2015. A Laboratory Manual to Accompany: General Biology II. American University: Washington, DC. Palleroni, N.J. (1984) Pseudomonadaceae. In Bergey's Manual of Systematic Biology. Kreig, N.R., and Holt, J.G. (eds). Baltimore: The Williams and Wilkins Co., pg. 141-199. "Ralstonia Pickettii." JGI Genome Portal - Home. Web. 25 Apr. 2010. <http://genome.jgi-psf.org/ralpd/ralpd.home.html>.
RJ
Embryology and Development in Zebrafish UPDATE 3/4/15
These are the updates for Day 7. We have yet to observe for Day 11 and Day 14.
On day 7, we fed the zebrafish paramecium and also added 10 mLs of water to the control and 10 mLs water plus the ethisterone to the test sample. We fixed one zebrafish from the control and one from the tested and added 1 drop off tricaine solution per mL of water. We then observed them under the microscope.
In the control group, there were 18 living zebrafish and none dead. There was quick eye movement and heart beat (couldn't count the exact heart rate because of quick movement). There were 2 fins, normal swim development, and about 3.5 mm long.
Here is a picture of the control zebrafish. 
In the tested group, there were 12 living zebrafish and one dead. There was very quick eye movement (more than control group) and their bodies were a lot skinner than the control groups as well. We couldn't find a heart beat and there were 2 pectoral fins which were also skinner than the control groups. The swim bladder was a lot larger than the control groups and was moving a lot faster and in quick, sudden movements than the control group. These were about .52 mm long.
Here is a picture of the test zebrafish.  The zebrafish in the test group are also a lot more sensible to light. They swim away from the pipette whenever it is placed in the petri dish. Their overall reactions and movement is faster than the control group.
The zebrafish in the test group are also a lot more sensible to light. They swim away from the pipette whenever it is placed in the petri dish. Their overall reactions and movement is faster than the control group.
Conclusion: The tested zebrafish's movements are being affected greatly. Their movement (eyes and body) is a lot quicker and more sudden than that of the control groups. The tested also have thinner bodies than the control. The response time of the tested is a lot quicker than that of the control group and are constantly moving even when the petri dish isn't touched. The ethisterone is obviously affected the zebrafish's body greatly, although, the death rate of the zebrafish is very low-- there was only one dead in the tested. Their bodies have grown in size substantially since day 4. RJ
Lab 6: Embryology and Development in Zebrafish 2/24/15
Purpose In this lab, we began our zebrafish experiment. In this experiment, my lab partner and I are treating zebrafish with ethisterone, a progestin treated to pregnant woman. We are doing this experiment in order to see how this progestin affects pregnant woman and the embryos/child of the woman. Also, to see how our environment/independent variables effect embryogenesis. Zebrafish are used in such experiments because they grow fast and their eggs are transparent, which makes it easy to observe the fish and see how it is being affected and in what body parts. In this lab, we also observe starfish development, frog development, and chick development in order to get an idea how development takes place in each of these animals. The zebrafish will be observed continuously for 2 weeks-- we will be observing the body size, behavior, mortality, etc.
Methods and Observations After reading our published paper, we decided to use ethisterone as our independent variable which will affect the zebrafish. Ethiserone is a progestin (female sex hormone) ingested by pregnant women. It has negative effects on women and their fetus. Being exposed to this progestin at different times of pregnancy effects the fetus in different ways as well. The earlier it is given, the harsher it effects the baby and the more negative the impact is. It affects the peripheral aspect of humans and also has a detrimental impact on the heart-- it causes many heart defects. We hypothesized that if fish are treated with concentrations of ethisterone, than the tested group will mature behaviorally faster than those of the control group. This is because ethisterone is a female sex hormone which means that the development of the fish will be faster than usual and will end up causing a lot of defects for the fish.
In this lab, we started off by having a control and a test group. We put 20 living zebrafish embryos into a "test" petri dish and 20 in a "control" petri dish. These fish were about 24-36 hours old. We then observed (under a microscope) the fish and their developments, as well as their characteristics and recorded our observations on an excel spread sheet. We also identified the zebrafish to be between 70% and 80% epiboly which you can see in this picture  . We then put in 20 mL of the ethisterone in the "test" petri dish and left it to observe the next day. When we observed the fish the next day, the control and the test zebrafish had eyes. We then observed the zebrafish on day 4 where we removed 10 mLs of the water and dead embryos. We saved the dead embryos in paraformaldehyde. We added 25 mLs of the test solution to the test dish and 25 mLs of water to the control petri dish. On day 4, the zebrafish hatched and again, we observed and recorded our data onto an excel sheet. We will be observing and recording the zebrafish on day 1, 4, 7, and 11 to see how the fish develop under the ethisterone condition and compare them to the control fish.
. We then put in 20 mL of the ethisterone in the "test" petri dish and left it to observe the next day. When we observed the fish the next day, the control and the test zebrafish had eyes. We then observed the zebrafish on day 4 where we removed 10 mLs of the water and dead embryos. We saved the dead embryos in paraformaldehyde. We added 25 mLs of the test solution to the test dish and 25 mLs of water to the control petri dish. On day 4, the zebrafish hatched and again, we observed and recorded our data onto an excel sheet. We will be observing and recording the zebrafish on day 1, 4, 7, and 11 to see how the fish develop under the ethisterone condition and compare them to the control fish.
Data and Observations This is a picture of the 2 petri dish: one was a control with 20 living zebrafish embryos and we made the other one a test with 20 living zebrafish embryos
 This is the ethisterone that we used in the "test" petri dish (20 mL)
This is the ethisterone that we used in the "test" petri dish (20 mL)
DAY 1 Observations:
Here is a picture of the control group we had observed:  They now have eyes and 2 of the embryos died with no hatchlings as of now. They also got bigger in size.
This is a picture of the test group:
They now have eyes and 2 of the embryos died with no hatchlings as of now. They also got bigger in size.
This is a picture of the test group:  They also have eyes and 3 of the embryos died. They grew in size and their were no hatchlings yet.
They also have eyes and 3 of the embryos died. They grew in size and their were no hatchlings yet.
DAY 4 Observations:
Here is a picture of the control group:  The average size is now 2mm and their are 18 living hatchlings. They now have tails and a body with organs.
Here is a picture of the test group:
The average size is now 2mm and their are 18 living hatchlings. They now have tails and a body with organs.
Here is a picture of the test group:  The average size is about .3mm. They are growing a lot slower in size than the control group and there are 13 living hatchlings.
The average size is about .3mm. They are growing a lot slower in size than the control group and there are 13 living hatchlings.
We will continue observing the developments in our next lab-- which we are recording on our excel sheet thus far.
Conclusion and Future Direction As of right now the test group is growing a lot slower than the control group. The control group has more dead hatchlings than the test group. All the zebrafish have eyes, tails, and are motile. It is important to know how these zebrafish are affected in order to learn how humans can be affected by ethisterone. These research and findings are extremely beneficial because it can facilitate in helping to find cures for such progestins and also eliminate occurrences from happening even before they take place. In this way, pregnant women can be careful about consuming ethisterone and be a lot more aware of the negative affects it would have on their children while in their womb and even after they are born. My lab partner and I will continue observing the zebrafish for 2 weeks and will record our observations.
References: Bentley, M., Walters-Conte, K., & Zeller, N. 2015. A Laboratory Manual to Accompany: General Biology II. American University: Washington, DC.
RJ
'1.27.15
Good first lab book entry. Need some more detail including Hay Infusion description.
SK
Lab 1: Observations of Abiotic and Biotic Species In an AU Transect 1/21/15
Purpose To observe biological life at AU by researching a transect from a sample of soil/vegetation and creating a Hay Infusion Culture.
Methods and Observations
We observed a transect right in front of Hurst Hall. Our transect included a patch of grass and soil with plants/bushes and a cement wall. We found ten abiotic and biotic components in this transect. We placed samples from the soil and vegetation in a 50 mL conical tube and did a Hay Infusion Culture to observe the organisms on our transect. We then left the open jar in lab in order to observe the culture in our next lab. We also observed members of the Volvocine line, which included Chlamydomonas, Gonium, and Volvox and compared/observed several characteristics of each. We determined the number of cells, colony size, specialization of cells, mechanisms of motility, isogamous or oogamous, and drew a picture of each member.
Date and Observations
Our transect:
 In the transect drawn above we found 5 abiotic components: snow, soil, wood chips, cement, and a fork. We also found 5 biotic specimens: grass, a flower bud, leaves, plants/bushes, spiders.
In the transect drawn above we found 5 abiotic components: snow, soil, wood chips, cement, and a fork. We also found 5 biotic specimens: grass, a flower bud, leaves, plants/bushes, spiders.
The Volvocine Line and the Evolutionary Specialization of its Members:

In the table above we observed the different members of the Volvocine line and compared them to one another. These show the evolution of the cells over time.
Conclusions and Future Direction The volvocine line proves that evolution does take place over time by observing the characteristics of the cells over time. We will be using the Hay Infusion Culture in our next lab to observe the protists and biological life in the sample we have collected.
2.4.15 Excellent notebook entry. Could have included a little more detailed description of protists found in the Hay Infusion. Each lab entry should be entered at the top of the page, moving older entries down. SK
Lab 2: Identifying Algae and Protists 2/2/15
Purpose In this lab, our main goal was to observe the protists and algae from the Hay Infusion Culture we created in the last lab. Our main goal is to study unicellular eukarya in this lab. We wanted to identify which organisms were in our culture using the dichotomous key and then sampling and observing different parts of the Hay Infusion Culture to understand what kind of organisms are in the different niches. We did this by preparing serial dilutions so we can observe the niches in the Hay Infusion Culture in lab 3. In this way, we can know the identities of which organisms were in our transect and their different characteristics.
Materials and Methods For the first part of the lab, we observed eukarya from the Hay Infusion Culture we made last week. We took samples from different parts of the Hay Infusion Culture. For example, some from the top of the water, some from the bottom, some from near a flower bud, etc. and put them on slides. We then observed those slides under a microscope in order to figure out what kind of organisms were in our culture. After seeing the characteristics of the protists and algae, we used the dichotomous key to identify which organism is which. A dichotomous key is a key where there are two choices of characteristics about the organism and whichever is correct, is the one you choose. From there you have to choose from two other choices and so on. There are choices about many kinds of characteristics an organism would have such as it's shape, color, number of cells, etc. From our observations, we found paramecium aurelia, eudorina, paramecium bursana, euglena, chlamydomonas, and paramecium multimicroneotum. For the second part of our lab, we prepared serial dilutions to use for next weeks lab to study prokaryotes. We took 3 tubes of 10 mLs sterile broth and labeled them with 10^-4, -6, and -8. Then we took 3 agar plates and 3 agar plates with tetracycline (an antibiotic) and labeled those. We then added 100 microliters of the Hay Infusion Culture into the tube 10^-4 and then added 100 microliters of 10^-4 into 10^-6 and same from 10^-6 into 10^-8. After this, we put 100 microliters of the culture from the 10^-4 tube onto the 10^-5 agar plates, 10^-6 onto 10^-7 agar plates, and 10^-8 onto 10^-9 agar plates. We then left the agar plates with tetracyline and without in the lab room to incubate.
Data and Observations
This one picture of organisms we observed under the microscope. 
This is an example of a dichotomous key: 



We found three organisms from samples from the bottom of the water: paramecium aurelia (150 um), eudordina (10 um), and paramecium bursana (80 um).. We found three from the flower bud: euglena (40 um), chlamydomoras (10 um), and paramecium multumicronucleatum (200 um). We found these using the dichotomous key starting with the front page of characteristics and following the number choices to the next options and so on until we identified the organisms. The organisms were tiny and most were moving throughout the specimen. They were all in different shapes and sizes (as shown in the pictures above). Their characteristics also varied a great amount.
Conclusions and Future Decisions From this lab, it is very obvious that there are many different kinds of eukarya in the Hay Infusion Culture which means there are a lot in our transect. We found 6 just in a bottle of our culture. All the organisms had different characteristics such as their movement and how they move, the number of cells, their shape, size, etc. This shows that their are many organisms on our planet that are always around us and we don't even realize it. We were able to make accurate identifications of our organisms because their structures and characteristics were pretty easy to read. The organisms we found were really small and usually were constantly moving. Some had flagella some didn't and others had numerous cells when others didn't. Each organism varied a lot depending on what kind they were and it was obvious from our findings through the dichotomous key. We will be using the agar plates we made in our next lab to identify prokaryotes.
RJ
2.11.15 Very good notebook entry. Well structured and clear. Could have included a link to gram stain protocol, rotated serial dilution image 90 degrees and mentioned what gene you were amplifying in the PCR reaction. SK
Lab 3: Microbiology and Identifying Bacteria with DNA Sequences 2/3/15
Purpose The purpose of this lab was to identify and study prokaryotes from the agar plates with and without tetracyline. We made observations of the Hay Infusion Culture again and then observed the agar plates including the number of colonies their were on each plate as well as their characteristics through observing slides under a microscope and making wet mounts/gram stains. We were able to observe the motility and different bacteria characteristics through these procedures. We also wanted to know if the antibiotic was resistant or not to the organisms we were observing. At the end of the lab we set up PCR for next weeks lab.
Materials and Methods
At first, we observed the Hay Infusion Culture again and made note of the changes from last week. The culture was a lot darker, the water had evaporated, and it did not smell as poorly/strongly as it did last week. We thought that this was because there weren't enough nutrients left for the organisms so they died off . We then observed the agar plates with and without tetracyline and counted the number of colonies in each plate. Here is a picture of the data we collected:  The plates without the tetracyline had a lot more colonies than the ones without the antibiotic. In the tetracyline plates, however, not all of the colonies/bacteria were resistant so they died off and others were still able to grow and multiply. Overall, the tetracyline did reduce the number of colonies than on the agar plates without the tetracyline which shows that many bacteria were resistant and some were not. There was no fungi in our agar plates and 2 out of 3 of the agar plates with tetracyline were affected a good amount. Tetracyline binds to ribosomes of bacteria which prevents a tRNA from attaching to the RNA complex and inhibits other protein synthesis processes as well. They are used for many different kinds of infections however, do not work as well anymore because most bacteria are now resistant to this antibiotic. (http://www.chm.bris.ac.uk/motm/tetracycline/antimicr.htm)
In the next part of our lab, we observed some prepared slides under a microscope of different kinds of bacteria and noted their characteristics after immersing them with oil and observing them under 100x. Next, we did a wet mount procedure where we scraped off certain colonies from 2 agar plates with tetracyline and 2 without. We put the growth on a plate and then put a drop of water on the slide. We observing the organisms under a microscope with 10x and 40x in order to determine the shape and motility of the organisms. After that, we did a gram stain procedure where we took off a grown from the agar and placed it on a slide and passed it through the flame. Then we covered it with crystal violet and then Gram's iodine mordant and proceeded to decolorize the bacteria. We then used safranin stain and blotted the excess water and proceeded to observe the slides under the 40x and 100x (with oil) in the microscope.
We then set up the PCR for next weeks lab where we transferred colonies and centrifuged them.
The plates without the tetracyline had a lot more colonies than the ones without the antibiotic. In the tetracyline plates, however, not all of the colonies/bacteria were resistant so they died off and others were still able to grow and multiply. Overall, the tetracyline did reduce the number of colonies than on the agar plates without the tetracyline which shows that many bacteria were resistant and some were not. There was no fungi in our agar plates and 2 out of 3 of the agar plates with tetracyline were affected a good amount. Tetracyline binds to ribosomes of bacteria which prevents a tRNA from attaching to the RNA complex and inhibits other protein synthesis processes as well. They are used for many different kinds of infections however, do not work as well anymore because most bacteria are now resistant to this antibiotic. (http://www.chm.bris.ac.uk/motm/tetracycline/antimicr.htm)
In the next part of our lab, we observed some prepared slides under a microscope of different kinds of bacteria and noted their characteristics after immersing them with oil and observing them under 100x. Next, we did a wet mount procedure where we scraped off certain colonies from 2 agar plates with tetracyline and 2 without. We put the growth on a plate and then put a drop of water on the slide. We observing the organisms under a microscope with 10x and 40x in order to determine the shape and motility of the organisms. After that, we did a gram stain procedure where we took off a grown from the agar and placed it on a slide and passed it through the flame. Then we covered it with crystal violet and then Gram's iodine mordant and proceeded to decolorize the bacteria. We then used safranin stain and blotted the excess water and proceeded to observe the slides under the 40x and 100x (with oil) in the microscope.
We then set up the PCR for next weeks lab where we transferred colonies and centrifuged them.
Data and Observations We observed all these plates under 100x in the microscope.
This is a picture of the agar plates labeled 10^-5, 10^-7 and 10^-9 respectively. The top row is of the plates without tetracyline and the bottom is with tetracyline. As you can see the plates with the tetracyline have way less colonies than the ones without it. This shows that the antibiotic did have an affect on the bactera.
This is the first plate we had observed: 10^-7 colony label blue. We noticed that the colonies were blue, flat, smooth, glistening, and punctiform undulate. It was a gram stain positive. We couldn't find a cell to identify for this colony.

This is the second plate we observed: 10^-7 with tetracyline colony label yellow. It was yellow, smooth, glistening, flat, and punctiform entire. The cells were rod shaped, swimming/floating, and brownian. It was gram positive.

This is the third plate we observed: 10^-7 colony label white. It was white, smooth, glistening, flat, and puntiform undulated. It was cocci and rod shaped, small, and swimming. It was also gram positive.

This is the last plate we observed: 10^-7 colony label white. It was white, flat, smooth, glistening, light yellow, punctiform entire and was rod shaped. It was swimming/floating very slowly together and was bronian. The gram stain was negative.

Conclusion and Future Directions We found that the agar plates with the tetracyline antibiotic had affected the bacteria a good amount. The 10^-9 plate did not have any colonies left. The colonies decreased a great amount and our colonies were mostly white, yellow/orange, and blue. We were able to characterize the cells for 3 out of 4 of the colonies that we had observed. They all were moving and swimming around. At first, it was a little hard trying to find the cells but after a while it got easier and easier. We used oil to help find the gram stains and the cells itself. The gram stains were all positive except for the colony label white 10^-7 with tetracyline. They all also were rod shaped and were extremely small. The PCR we made are going to be used for next weeks lab to identify more bacteria and purifying DNA in order to sequence them.
RJ
2.19.15 Excellent lab book entry. New entries should be entered at the top of the page so the older entries get moved downward each week. SK
Lab 4: Plantae and Fungi 2/11/15
Purpose: The purpose of this lab was to observe and write down characteristics of five plant samples we collected from our transect. We recorded the location, size/shape, vascularization, specialized structures, and mechanisms of reproduction for each sample. We also had to observe characteristics of Mnium, which is a Bryophyte moss, and Lilium, an angiosperm. We then identified which lineage the moss is from. We also set up our next lab.
Materials and Methods: For the first part of this lab, we had to go outside and collect 5 samples from the transect. We also collected leaf litter to set up the Berlese funnel for next weeks lab. We used the same transect from lab 2. Here is a picture of the transect and where we got our 5 samples from:  Because of our current weather, the grass was basically dead and so were the plants/bushes. We were only able to collect 5 different leaves which we concluded were mostly dead or were swept into our transect from trees nearby. All of our samples were collected from the ground. We also collected leaves growing from under the flower bush or from a dead flower bud. Most of the leaves were dry but some were still alive. We made our observations and recorded them on a table. We characterized their colors, shapes, whether they were dead or not, their edges, height, whether they were xylem or phloem (or both), cuticle, dicot/monocot, and if they went through alternation of generation. Xylem and phloem are layers on plants/leaves that transport water and nutrients and can be observed from a cross section. The cuticle is the waxy layer on the leaf, which we observed just by touching it. A vascular plant is one that has xylem/phloem and can conduct certain processes, such as photosynthesis and providing nutrients throughout the plants. We concluded that all our samples were vascular and had xylem and phloem. Lastly, a monocot and dicot is the structure into which a leaf develops.
After identifying and recording our observations from our 5 samples, we observed a fungi through a microscope. The one we observed was a black bread mold and was from the ascomycota lineage, which are pathogenic.
Fungal sporangia is a fungi where spores are produced and is where meiosis takes place. It is important because this is the site at where fungi reproduce asexually and continue their life cycle as evolution keeps occurring. Fungi is an important part of the ecosystem so the need for fungi is pretty high since they do processes that are important for the balance of elements in our environment.
Citation: Asexual Sporangia. (n.d.). Retrieved February 11, 2015, from http://website.nbm-mnb.ca/mycologywebpages/NaturalHistoryOfFungi/AsexualSporangia.html
We also dissected and observed a lilium.
At the end of our lab, we set up the Berlese Funnel for our next lab to collect invertebrates. We poured 25 m of ethanol and water solution into a conical tube and then put screening material at the bottom of the funnel so the leaf liter doesn't fall into the flask preservative. We put the leaf litter in and then put the tube with the flask underneath under a light fixture. We will observe this funnel in our next lab.
Because of our current weather, the grass was basically dead and so were the plants/bushes. We were only able to collect 5 different leaves which we concluded were mostly dead or were swept into our transect from trees nearby. All of our samples were collected from the ground. We also collected leaves growing from under the flower bush or from a dead flower bud. Most of the leaves were dry but some were still alive. We made our observations and recorded them on a table. We characterized their colors, shapes, whether they were dead or not, their edges, height, whether they were xylem or phloem (or both), cuticle, dicot/monocot, and if they went through alternation of generation. Xylem and phloem are layers on plants/leaves that transport water and nutrients and can be observed from a cross section. The cuticle is the waxy layer on the leaf, which we observed just by touching it. A vascular plant is one that has xylem/phloem and can conduct certain processes, such as photosynthesis and providing nutrients throughout the plants. We concluded that all our samples were vascular and had xylem and phloem. Lastly, a monocot and dicot is the structure into which a leaf develops.
After identifying and recording our observations from our 5 samples, we observed a fungi through a microscope. The one we observed was a black bread mold and was from the ascomycota lineage, which are pathogenic.
Fungal sporangia is a fungi where spores are produced and is where meiosis takes place. It is important because this is the site at where fungi reproduce asexually and continue their life cycle as evolution keeps occurring. Fungi is an important part of the ecosystem so the need for fungi is pretty high since they do processes that are important for the balance of elements in our environment.
Citation: Asexual Sporangia. (n.d.). Retrieved February 11, 2015, from http://website.nbm-mnb.ca/mycologywebpages/NaturalHistoryOfFungi/AsexualSporangia.html
We also dissected and observed a lilium.
At the end of our lab, we set up the Berlese Funnel for our next lab to collect invertebrates. We poured 25 m of ethanol and water solution into a conical tube and then put screening material at the bottom of the funnel so the leaf liter doesn't fall into the flask preservative. We put the leaf litter in and then put the tube with the flask underneath under a light fixture. We will observe this funnel in our next lab.
Data and Observations Below is a picture of the five samples we collected and the plant characterization table of the five samples we collected. We collected our samples from our transect which is nearest to Hurst hall. We collected leaves, dead or still alive, from the ground near the dead plants/flowers. They were all from the ground and we concluded that some flew in from trees near by. We collected ones that were growing under the dead bush, from a bud on a dead flower, and from different sides of the ground. Leaf 1, 2, and 5 were from random parts of the ground and leaf 3 and 4 were from a flower and rose bud. Only leaf 2 did not have a cuticle but the rest did and were dicots. They all were vascular and their sizes ranged from 2 mm to 7 mm. The characterizations can be viewed on the Plant Characterization Table.

This is a picture of the bread mold we had observed and concluded was an ascomycota.

This is a picture of the Berlese Funnel we set up for next weeks lab.

Conclusion and Future Direction We concluded that there is much variety in plants in their characteristics. The way they reproduce, transfer nutrients, their size, shape, and the processes they go through all vary a lot. Plants and leaves are really important for our ecosystem because it helps proceed other processes as well which bring a balance to our earth. Fungi are also important in the same way and their are so many different kinds with different characterizations as well. One would not think how beneficial these organisms are on our planet but they are the ones that help us be able to live on earth and help other organisms as well. We are going to use the Berlese funnel for our next lab to identify invertebrate.
RJ
2.24.15 Good notebook entry. Newest entries should be at top of page, pushing older entries downwards. SK
Lab 5: Invertebrates 2/18/15
Purpose: The purpose of this lab we observed invertebrates and their different characteristics by identifying their movements, sizes, their classification, etc. Invertebrates can have either bilateral or radial symmetry and most consist of an ectoderm, endoderm, and mesoderm. Their are thousands of invertebrates that exist on our planet and we were able to identify several from observing our Berlese Funnel that we set up in last weeks lab. The Berlese Funnel consisted of leaf litter from our transect and ethanol/water. We also observed organisms just by looking at them and characterizing them from the naked eye and a microscope. Last week, we set up the Berlese Funnel using a conical tube full of 50:50 water/ethanol. We put a screening material in the funnel so leaf litter doesn't fall into the conical tube. We then filled the funnel with leaf litter, attached it to a ring stand, and put it under a lamp for a week. In this lab, we observed the preservatives that were in the ethanol/water conical tube that dripped down from the funnel tube and worked with this this week.
Materials and Methods: For the first part of the lab, we observed acoelomates, pseudocoelomates, and coelomates through the naked eye and a microscope. The acoelomate (Planaria) were tiny in a bottle of aqueous solution. They curled up in order to move and had straight bodies. They kept falling up and down from the top to the bottom of the solution. The nematodes and coelomates (annelida) were a lot bigger, their movement was slower, and they curled in to move. Since invertebrates do not have a vertebral column, these organisms were moving through their bodies consistently curling in and out, up and down to get from place to place. We also examined arthropods and organisms from the five classes: arachnida, diplopoda, chilopoda, insect, and crustacea. Their structures are a lot more complex then the previously observed invertebrates and they are able to move through the use of their claws and legs. Their features, such as their eyes and mouths, are a lot more visible than those of acoelomates, pseudocoelomates, and coelomates. They have a numerous amount of body parts/segments and they live either in water or on land. Lastly, we observed the Berlese Funnel we had made last week and left under a lamp for the invertebrates remains to be looked at. We poured out the organisms with the ethanol into a petri dish and observed the organisms under a microscope. We were only able to observe two organisms that existed in our transect. The sizes ranged from .1 cm to .3 cm -- they were very small and could not be observed by the naked eye. The most common organism was the soil mite. We were able to find 10 of them and they were about .1 cm long. They were extremely small, gray/clear color, had claws, were round, and had legs. We also found 1 springtail x soil mite. It was .3 cm long and it was gray with whiskers and legs. This part of the lab was very interesting because we observed organisms in our transect that we didn't even know existed and were so tiny that we could not see them from the naked eye. They both are arthropods and can live in different habitats. They can benefit through growing and feeding from the environment as well as providing nutrients for the ecosystem. They are involved in crop fielding, control pollination, etc. All of these organisms, including the rest of the community, help another other whether it be through feeding, providing nutrients, providing energy, or even chemicals to the air which we need on a daily basis. The different trophic levels use one another in order to provide for another another and help each other live on this planet.
Data and Observations
These are pictures of acoelomates, pseudocoelomates, and coelomates we observed:


These are pictures of the Berlese Funnel observations we made:
In this one you can see the springtail x soil mite: 
This one contains the .1 cm soil mites. There are many in this one microscopic view. 
Here is a picture of the Berlese Funnel chart we made in class of the organisms: 
This is an example of a food web I created based off of my research : 
Conclusion and Future Directions There are many different kinds of invertebrates. Whether they move through a curling in movement or they actually have legs and a more complex system/structure. They live in different kinds of environment and range in size from only being about to be seen under a microscope to ones that are as big as a human head. Invertebrates have different characteristics as well as where they live and how they live. They feed in various ways and end up helping each other and the ecosystem. There are many kinds of invertebrates and I wish we could have examined more if we had more time. Our transect consists of so many kinds of bacteria, eukaryotes, prokaryotes, and invertebrates which makes the world even more fascinating. They all live together and have a beneficial relationship with one another to help us live on Earth everyday.
Citation : Cosmato, D. (2013, January 24). The Ecological Importance of Arthropods - Know the Economic Benefits of Diversity. Retrieved February 18, 2015, from http://www.brighthub.com/environment/science-environmental/articles/85197.aspx
RJ
